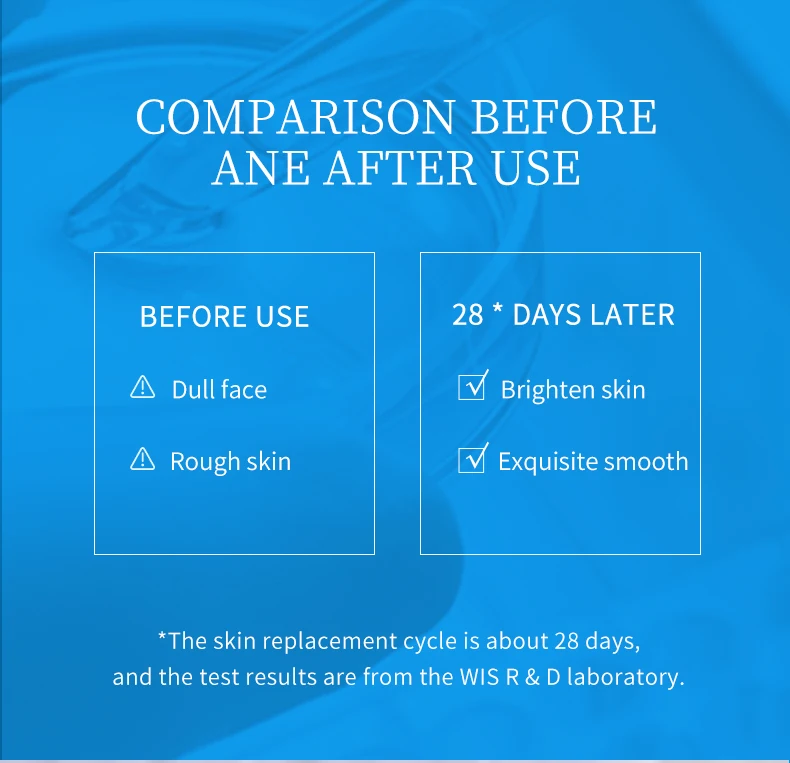
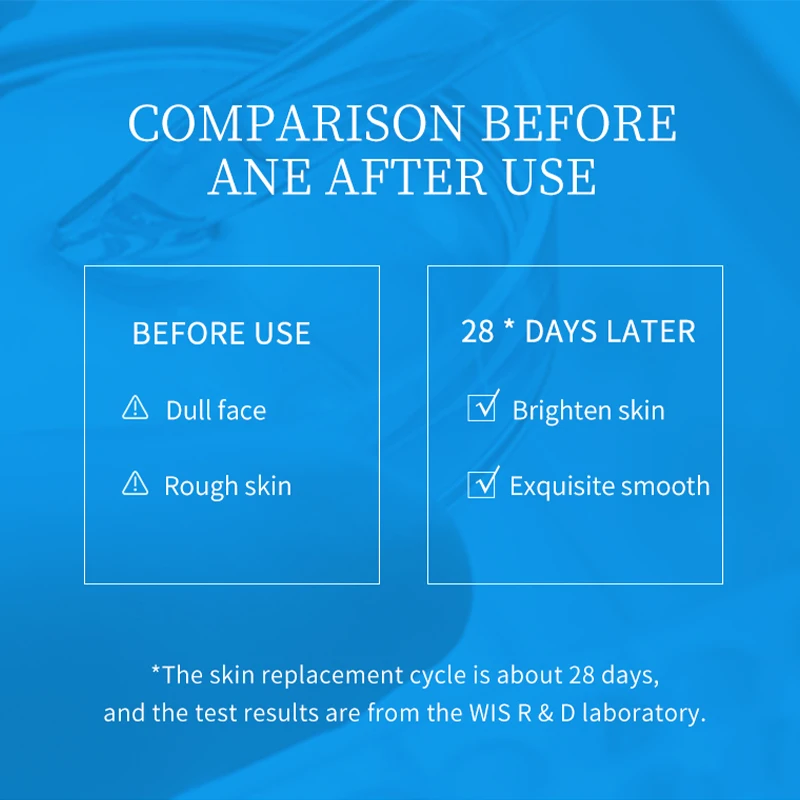
WIS отшелушивающее очищающее средство для лица Увлажняющий мусс очищения

WIS отшелушивающее очищающее средство для лица Увлажняющий мусс очищения
Сохраните в закладки:






История цены
*История изменения цены! Указанная стоимость возможно, уже изменилось. Проверить текущую цену - >
| Месяц | Минимальная цена | Макс. стоимость | Цена |
|---|---|---|---|
| Feb-20-2026 | 4139.26 руб. | 4222.93 руб. | 4180.5 руб. |
| Jan-20-2026 | 3357.45 руб. | 3424.81 руб. | 3390.5 руб. |
| Dec-20-2025 | 4074.56 руб. | 4155.77 руб. | 4114.5 руб. |
| Nov-20-2025 | 4041.5 руб. | 4122.64 руб. | 4081.5 руб. |
| Oct-20-2025 | 3226.1 руб. | 3291.81 руб. | 3258.5 руб. |
| Sep-20-2025 | 3976.99 руб. | 4056.56 руб. | 4016 руб. |
| Aug-20-2025 | 3943.68 руб. | 4022.95 руб. | 3982.5 руб. |
| Jul-20-2025 | 3911.5 руб. | 3989.2 руб. | 3950 руб. |
Новые товары
BIOAQUA VENZEN бамбуковый уголь очищающий ледяные кристаллы увлажняющий сжимающий
Детоксикационный крем с бамбуковым углем глубокий питательный массажный для
Уход за кожей лицо Сашель Биобаланс крем-филлер для очищения кожи с
Очищающая пенка для лица ультра увлажняющая Missha Super Aqua 10 Hyaluronic Acid Ultra Hyalon Foaming Cleanser
Оригинальный натуральный старый китайский цветок пчелы Fenghua Myricyl сандаловое
Заживляющий гель гиалуроновый после депиляции эпиляции постакне лечение от
Убтан Кавказский для лица "Бизорюк" "Лечение" 130 мл | Красота и здоровье
Активированный бамбуковый уголь органическое управление мылом ручной работы
Характеристики
WIS отшелушивающее очищающее средство для лица Увлажняющий мусс очищения
Описание товара
WIS очищающий Отшелушивающий мусс для лица пилинг гель плавное Увлажнение Маска для уменьшения пор контроль масла глубокая пор Очищающая, отбеливающая
Шаги по использованию:
1. Аккуратно встряхните бутылку, насадка наклоняется к ладони 2. Нанесите на все лицо или области, где необходимо удалить Кератин 3. Мягко массируйте 20S, чтобы вытереть старые отходы 4. Краску в чистой воде для ухода за кожей
Эффективность:
1. Удаляет омертвевшие клетки кожи, очищает поры и открывает каналы кожи 2. Удаляет жирные, сохраняет кожу свежей, избавляет от акне и черных точек 3. Попрощайтесь с грубой и тусклой кожей, нежной и сбалансированной кожей, чтобы показать естественный блеск 4. Равномерно сияющая кожа, сияющая кожа, попрощайтесь с тусклым 5. Растительный коллаген придает коже эластичность, гладкость и нежность 6. Баланс воды и масла кожи, стабилизирует кожу, улучшает жирность и шероховатость
Информация о продукте:
Тип: Отшелушивающий мусс Тип кожи: все типы кожи Пол: унисекс Состав: экстракт глицирризы глабра, Экстракт центеллы азиатской, экстракт матрикарии Вес нетто: 150 мл Целевая область: лицевая сторона Посылка включает в себя: 1 шт WIS очищающий Отшелушивающий мусс

О доставке:
1. После размещения заказа, мы организуем доставку в течение 2 дней, и мы будем задерживать 1-2 дня в выходные дни 2. Срок доставки в большинстве стран составляет 20-40 дней, отдаленные страны или особые обстоятельства около 60 дней 3. Если вы не получили товар, пожалуйста, свяжитесь с нами.
О Отзывы:
1. Если вы удовлетворены нашим обслуживанием и продуктами, надеемся, что вы дадите нам 5 звезд положительные отзывы. Ваша поддержка много значит для нас. 2. Если у вас есть какие-либо вопросы, пожалуйста, свяжитесь с нами, мы поможем вам решить их! 3. Цель WIS-удовлетворение потребностей клиентов!
О WIS:
WIS-бренд, разработанный в сотрудничестве со швейцарской компанией. Он представляет передовые технологии и сырье швейцарской группы RAHN, производит косметику в соответствии со стандартами лекарственных средств, преследует научные и эффективные идеи и стремится сделать уход за кожей более научным и эффективным, привнесение молодых потребителей к прекрасному опыту кожи.
Трекер стоимости
Отзывы покупателей
Новые отзывы о товарах
Заказала на али такое зарядное устройство и стало намного легче. А то раньше одной зарядкой по очереди пользовались, а теперь... Читать отзыв полностью...
Такой чайник я видел у своего соседа, когда пил чай. Хорошая вещь! Удалось даже самому пользоваться. Удобный, прочный, прекрасно заваривает... Читать отзыв полностью...
Хочу выразить благодарственно за отличный велосипед, ни разу не пожалел что заказ. Приобрёл велосипед для семьи, переодически гоняем на нем... Читать отзыв полностью...
Отличный горный велосипед! Доволен покупкой очень, рекомендую! Если вы любитель провести время экстремально и где-то за пределами города, то этот... Читать отзыв полностью...
Долго выбирал горный велосипед, никак не мог определиться. В итоге остановился на данной модели (FOREVER Р6-6) и не прогадал! Все... Читать отзыв полностью...
Мягкое, длинное, теплое, приятное на ощупь платье. Терпеть не могу, когда трикотаж "скрипит". Очень уютное. Полноразмерное (не маломерка). рукава длинные,... Читать отзыв полностью...

Простой и портативный прибор, хороший инструмент для определения диапазона подвижности сустава. Поможет выявить врожденные и приобретенные двигательные проблемы, оценить функциональное... Читать отзыв полностью...